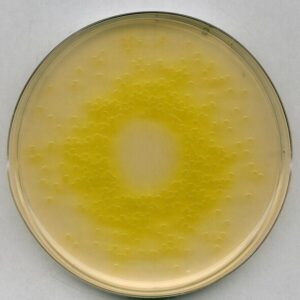

La Grapadora Lineal Recargable PURPLE SURGICAL ULTIMATE coloca dos filas dobles de grapas de titanio, corta y divide simultáneamente el tejido entre las dos filas dobles.
La Grapadora Lineal Recargable PURPLE SURGICAL ULTIMATE está disponible en longitudes de grapas de 60 mm, 80 mm y 100 mm con unidades de recarga disponibles tanto para el tejido estándar (3.8 mm) como para el tejido grueso (4.8 mm). Cada dispositivo puede recargarse hasta 7 veces para un máximo de 8 disparos por paciente. El diseño ergonómico, con incrustaciones de agarre de goma y palanca doble flexible para disparos básicos de mano izquierda o derecha, facilita la comodidad y el control del usuario. La formación de grapas crea el engrapado en forma de «B» perfecto en todos y cada uno de los disparos para mejorar el rendimiento clínico.
Las características y los beneficios incluyen:
- Nueva cuchilla con cada cartucho garantiza una transección suave y precisa con cada disparo, reduciendo el riesgo de infección cruzada.
- Mecanismo automático de bloqueo de seguridad incorporado dentro de cada cartucho.
- La bisagra trasera permite operar el dispositivo con una mano.
- La palanca de disparo ajustable le permite disparar desde cualquier lado del dispositivo.
- Palanca dual con capacidad de disparo de lados izquierdo y derecho.
- Botón de liberación rápida permitiendo operar el dispositivo con sola mano.
- Mango ergonómico con agarres de goma para control adicional.
La anatomía adecuada para este dispositivo incluye:
- Cirugía general – estómago, duodeno, intestino pequeño, hígado, colon
- Cirugía ginecológica – Tubos de Falopio, ovarios
- Cirugía urológica – vejiga
- Cirugía torácica – Parénquima